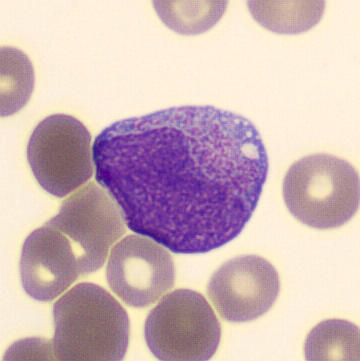
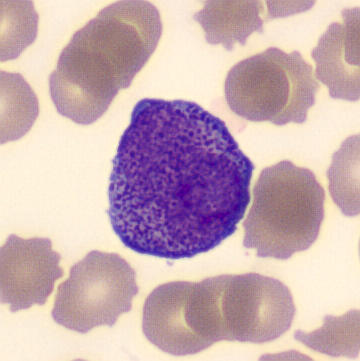

WDF - LAP
SFL
SSC

Lymphocytes
Monocytes
Neutrophiles
Éosinophiles
Basophiles
La population leucocytaire diffuse aberrante avec un signal SFL élevé se situe entre les monocytes normaux et les granulocytes immatures. Cette diffusion WDF est observée dans la leucémie promyélocytaire aiguë hypergranulaire.
Morphologie possible